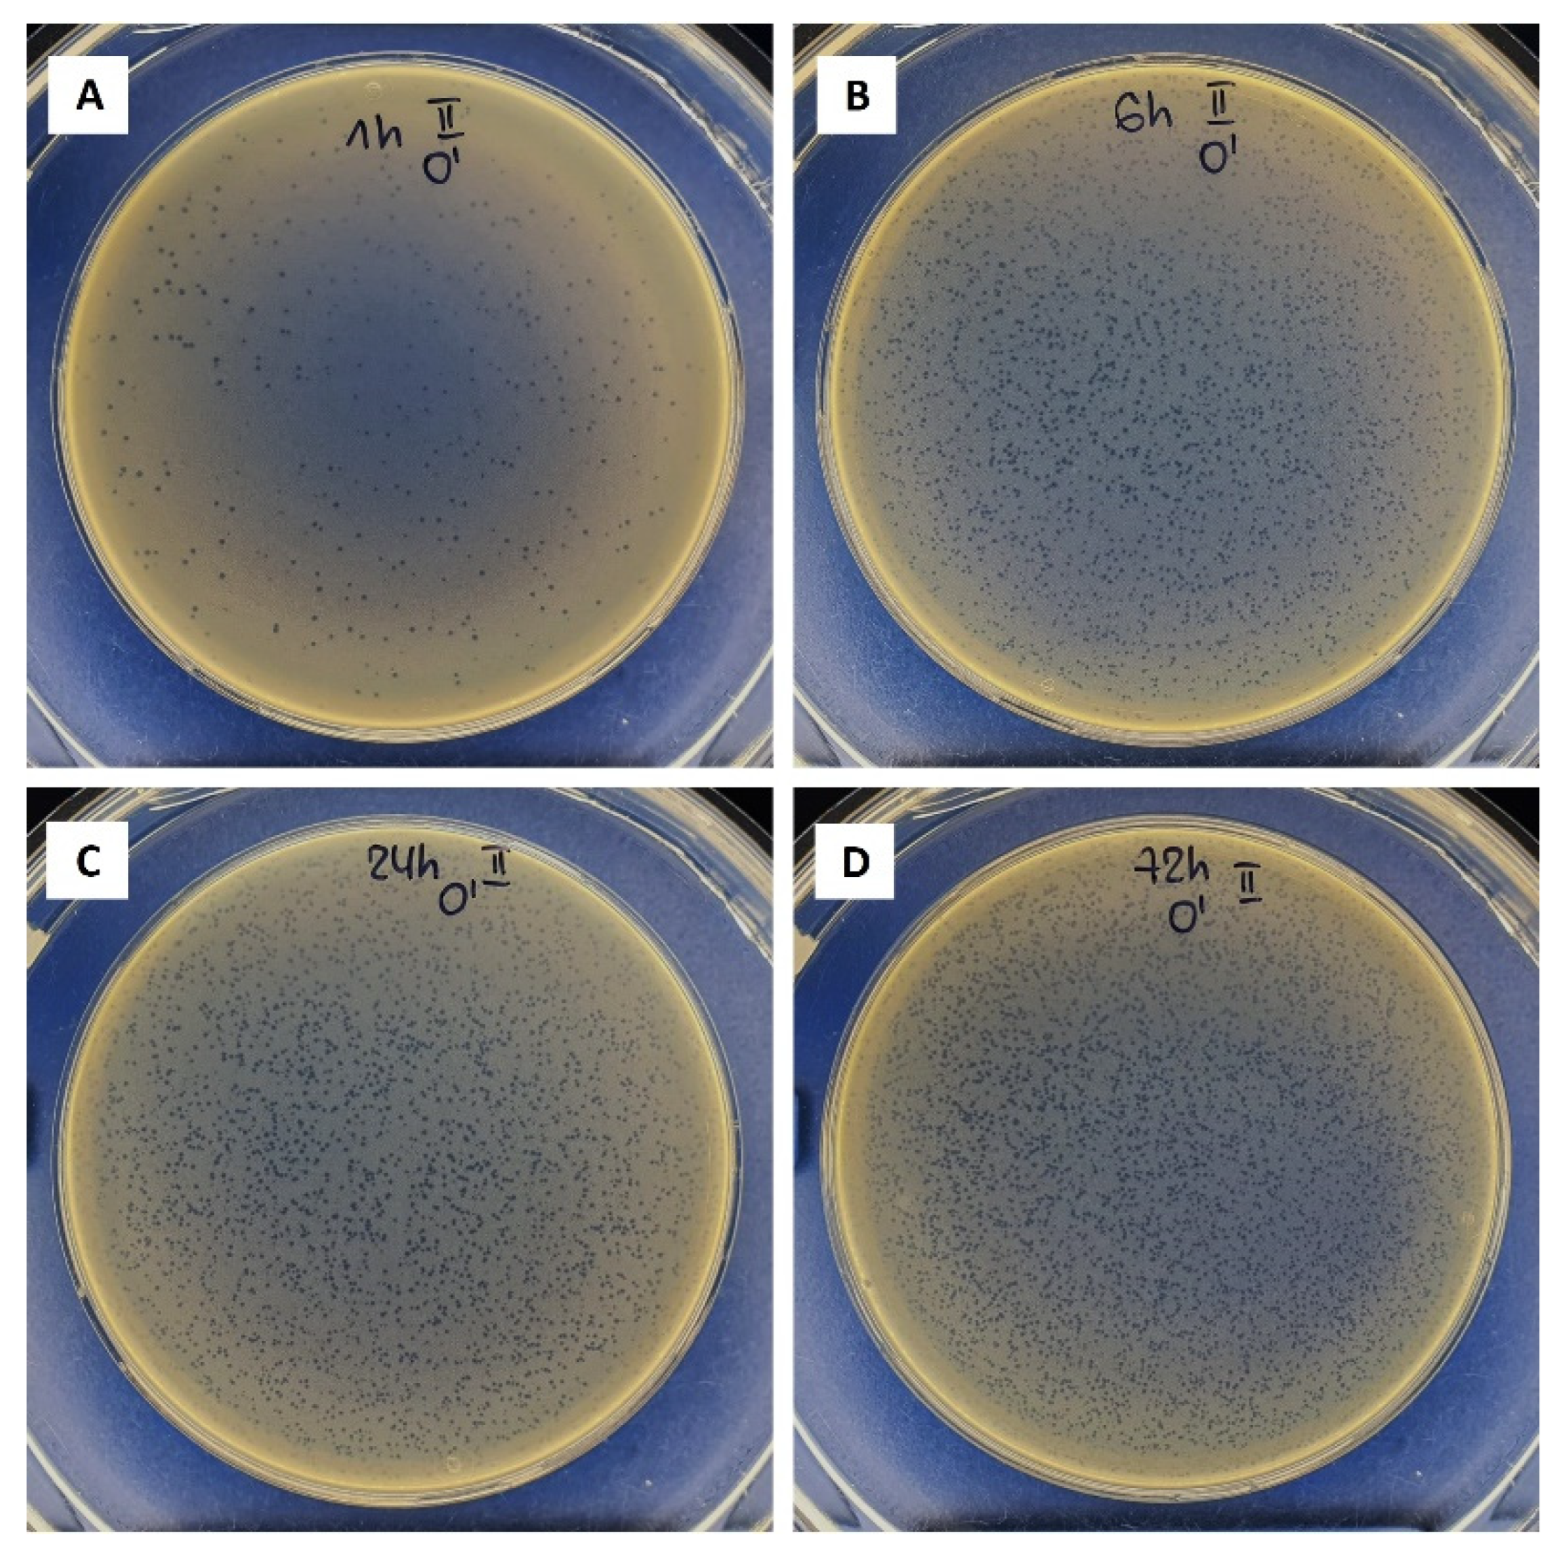
Biomolecules 12 01875 g006

Effect of the Biopolymer Carrier on Staphylococcus aureus Bacteriophage Lytic Activity
Abstract
1. Introduction
2. Materials and Methods
2.1. Sample Preparation
2.1.1. Preparation of the Bacteriophage Solutions
- Culturing of the host bacterial strain. A solid agar plate was inoculated with the host strain (reference strain S. aureus (ATCC 25923)) and incubated overnight at 37 °C. Furthermore, the 3–5 bacterial colonies grown on the plate were inoculated in a liquid medium (trypticase soy broth (TSB, Oxoid, Basingstoke, Hampshire, UK)) and incubated overnight at 37 ± 1 °C.
- Performing the plaque assay to determine the concentration of the bacteriophage cocktails. In test tubes, the overnight-grown host strain was mixed with serially diluted Staphylococcal and Pyo Bacteriophage cocktails. Then, 5 mL of molten 0.7% trypticase soy agar (TSA, Oxoid, Basingstoke, Hampshire, UK) was transferred to each test tube, and the obtained mixture was poured onto a solid TSA plate. After the top agar was solidified, the plates were inverted and placed in the incubator overnight at 37 ± 1 °C. The number of plaque-forming units per mL (PFU/mL) was counted.
- Propagating commercial bacteriophage stocks to obtain higher titre bacteriophage lysates. After plaque assay testing, the webbed plates were selected and flooded with 5–7 mL of TSB. The supernatant and soft-overlay agar was selected. Afterwards, a 2% chloroform (CHCl3) treatment for 2 h at 4 °C, the removal of bacterial debris using centrifugation at 6000× g for 15 min at 4 °C, and filtration using a 0.20 μm filter were performed. The supernatant was then collected, and the final concentration (titre in terms of plaque-forming units per millilitre (PFU/mL)) was determined using plaque assay according to Equation (1):
2.1.2. Preparation of the Mixtures of Biopolymers/Bacteriophages
2.2. Characterization
3. Results and Discussion
3.1. Bacteriophages Propagation
3.2. Molecular Structure of the Biopolymers
3.3. Bacteriophages Stability
3.4. Ca-Alginate Stability and Bacteriophages Release
4. Conclusions
Author Contributions
Funding
Institutional Review Board Statement
Informed Consent Statement
Data Availability Statement
Conflicts of Interest
References
- Lu, Y.; Cai, W.J.; Ren, Z.; Han, P. The Role of Staphylococcal Biofilm on the Surface of Implants in Orthopedic Infection. Microorganisms 2022, 10, 1909. [Google Scholar] [CrossRef] [PubMed]
- Rosas, S.; Ong, A.C.; Buller, L.T.; Sabeh, K.G.; Law, T.Y.; Roche, M.W.; Hernandez, V.H. Season of the year influences infection rates following total hip arthroplasty. World J. Orthop. 2017, 8, 895–901. [Google Scholar] [CrossRef] [PubMed]
- Johnson, C.T.; Garcia, A.J. Scaffold-based anti-infection strategies in bone repair. Ann. Biomed. Eng. 2015, 43, 515–528. [Google Scholar] [CrossRef]
- Kim, B.-N.; Kim, E.S.; Oh, M.-D. Oral antibiotic treatment of staphylococcal bone and joint infections in adults. J. Antimicrob. Chemother. 2014, 69, 309–322. [Google Scholar] [CrossRef] [PubMed]
- Wassif, R.K.; Elkayal, M.; Shamma, R.N.; Elkheshen, S.A. Recent advances in the local antibiotics delivery systems for management of osteomyelitis. Drug Deliv. 2021, 28, 2392–2414. [Google Scholar] [CrossRef]
- Katsikogianni, M.; Missirlis, Y.F. Concise review of mechanisms of bacterial adhesion to biomaterials and of techniques used in estimating bacteria-material interactions. Eur. Cells Mater. 2004, 8, 37–57. [Google Scholar] [CrossRef] [PubMed]
- Campoccia, D.; Montanaro, L.; Renata, C. The significance of infection related to orthopedic devices and issues of antibiotic resistance. Biomaterials 2006, 27, 2331–2339. [Google Scholar] [CrossRef] [PubMed]
- Romanò, C.L.; Scarponi, S.; Gallazzi, E.; Romanò, D.; Drago, L. Antibacterial coating of implants in orthopaedics and trauma: A classification proposal in an evolving panorama. J. Orthop. Surg. Res. 2015, 10, 157. [Google Scholar] [CrossRef]
- Blair, J.M.A.; Webber, M.A.; Baylay, A.J.; Ogbolu, D.O.; Piddock, L.J.V. Molecular mechanisms of antibiotic resistance. Nat. Rev. Microbiol. 2015, 13, 42–51. [Google Scholar] [CrossRef]
- Racenis, K.; Rezevska, D.; Madelane, M.; Lavrinovics, E.; Djebara, S.; Petersons, A.; Kroica, J. Use of phage cocktail BFC 1.10 in combination with ceftazidime-avibactam in the treatment of multidrug-resistant Pseudomonas aeruginosa femur osteomyelitis—A case report. Front. Med. 2022, 9, 851310. [Google Scholar] [CrossRef]
- Qadir, M.I.; Mobeen, T.; Masood, A. Phage therapy: Progress in pharmacokinetics. Braz. J. Pharm. Sci. 2018, 54, e17093. [Google Scholar] [CrossRef]
- Monk, A.B.; Rees, C.D.; Barrow, P.; Hagens, S.; Harper, D.R. Bacteriophage applications: Where are we now? Lett. Appl. Microbial. 2010, 51, 363–369. [Google Scholar] [CrossRef] [PubMed]
- Thung, T.Y.; Lee, E.; Premarathne, J.M.K.J.K.; Nurzafirah, M.; Kuan, C.H.; Elexson, N.; Tan, C.W.; Malcolm, T.T.H.; New, C.Y.; Ramzi, O.S.B.; et al. Bacteriophages and their applications. Food Res. 2018, 2, 404–414. [Google Scholar] [CrossRef]
- Davies, E.V.; Winstanley, C.; Fothergill, J.L.; James, C.E. The role of temperate bacteriophages in bacterial infection. FEMS Microbiol. Lett. 2016, 363, fnw015. [Google Scholar] [CrossRef]
- Hyman, P. Phages for phage therapy: Isolation, characterization, and host range breadth. Pharmaceuticals 2019, 12, 35. [Google Scholar] [CrossRef]
- Fulgione, A.; Ianniello, F.; Papaianni, M.; Contaldi, F.; Sgamma, T.; Giannini, C.; Pastore, S.; Velotta, R.; Della Ventura, B.; Roveri, N.; et al. Biomimetic hydroxyapatite nanocrystals are an active carrier for Salmonella bacteriophages. Int. J. Nanomed. 2019, 14, 2219–2232. [Google Scholar] [CrossRef]
- Vasilev, K.; Cook, J.; Griesser, H.J. Antibacterial surfaces for biomedical devices. Expert Rev. Med. Devices 2009, 6, 553–567. [Google Scholar] [CrossRef]
- Zimmerli, W. Clinical presentation and treatment of orthopaedic implant-associated infection. J. Intern. Med. 2014, 276, 111–119. [Google Scholar] [CrossRef] [PubMed]
- Choinska-Pulit, A.; Mitula, P.; Sliwka, P.; Laba, W.; Skaradzinska, A. Bacteriophage encapsulation: Trends and potential applications. Trends Food Sci. Technol. 2015, 45, 212–221. [Google Scholar] [CrossRef]
- Lone, A.; Anany, H.; Hakeem, M.; Aguis, L.; Avdjian, A.C.; Bouget, M.; Atashi, A.; Brovko, L.; Rochefort, D.; Griffiths, M.W. Development of prototypes of bioactive packaging materials based on immobilized bacteriophages for control of growth of bacterial pathogens in foods. Int. J. Food Microbiol. 2016, 217, 49–58. [Google Scholar] [CrossRef]
- O’Connell, L.; Marcoux, P.R.; Roupioz, Y. Strategies for Surface Immobilization of Whole Bacteriophages: A Review. ACS Biomater. Sci. Eng. 2021, 7, 1987–2014. [Google Scholar] [CrossRef] [PubMed]
- Rebelo, R.; Fernandes, M.; Fangueiro, R. Biopolymers in medical implants: A brief review. Procedia Eng. 2017, 20, 236–243. [Google Scholar] [CrossRef]
- Stipniece, L.; Salma-Ancane, K.; Rjabovs, V.; Juhnevica, I.; Turks, M.; Narkevica, I.; Berzina-Cimdina, L. Development of functionalized hydroxyapatite/poly(vinyl alcohol) composites. J. Cryst. Growth 2016, 444, 14–20. [Google Scholar] [CrossRef]
- Hosseinidoust, Z.; Olsson, A.L.J.; Tufenkji, N. Going viral: Designing bioactive surfaces with bacteriophage. Colloids Surf. B Biointerfaces 2014, 124, 2–16. [Google Scholar] [CrossRef]
- Munoz-Bonilla, A.; Echeverria, C.; Sonseca, A.; Arrieta, M.P.; Fernandez-Garcia, M. Bio-based polymers with antimicrobial properties towards sustainable development. Materials 2019, 12, 641. [Google Scholar] [CrossRef] [PubMed]
- Szekalska, M.; Pucilowska, A.; Szymanska, E.; Ciosek, P.; Winnicka, K. Alginate: Current use and future perspectives in pharmaceutical and biomedical applications. Int. J. Polym. Sci. 2016, 2016, 7697031. [Google Scholar] [CrossRef]
- Rotman, S.G.; Sumrall, E.; Ziadlou, R.; Grijpma, D.W.; Richards, R.G.; Eglin, D.; Moriarty, T.F. Local bacteriophage delivery for treatment and prevention of bacterial infections. Front. Microbiol. 2020, 11, 538060. [Google Scholar] [CrossRef] [PubMed]
- Wang, Y.L.; Hu, J.J. Sub-100-micron calcium-alginate microspheres: Preparation by nitrogen flow focusing, dependence of spherical shape on gas streams and a drug carrier using acetaminophen as a model drug. Carbohydr. Polym. 2021, 269, 118262. [Google Scholar] [CrossRef]
- Kim, H.Y.; Chang, R.Y.K.; Morales, S.; Chan, H.K. Bacteriophage-delivering hydrogels: Current progress in combating antibiotic resistant bacterial infection. Antibiotics 2021, 10, 130. [Google Scholar] [CrossRef]
- Arciola, C.R.; An, Y.H.; Campoccia, D.; Donati, M.E.; Montanaro, L. Etiology of implant orthopedic infections: A survey on 1027 clinical isolates. Int. J. Artif. Organs 2005, 28, 1091–1100. [Google Scholar] [CrossRef]
- Kaplan, S.L. Recent lessons for the management of bone and joint infections. J. Infect. 2014, 68, S51–S56. [Google Scholar] [CrossRef] [PubMed]
- Appelbaum, P.C. The emergence of vancomycin-intermediate and vancomycin-resistant Staphylococcus aureus. Clin. Microbiol. Infect. 2006, 12, 16–23. [Google Scholar] [CrossRef] [PubMed]
- Abatángelo, V.; Bacci, N.P.; Boncompain, C.A.; Amadio, A.F.; Carrasco, S.; Suarez, C.A.; Morbidoni, H.R. Broad-range lytic bacteriophages that kill Staphylococcus aureus local field strains. PLoS ONE 2017, 12, e0187387. [Google Scholar] [CrossRef] [PubMed]
- Xia, G.; Wolz, C. Phages of Staphylococcus aureus and their impact on host evolution. Infect. Genet. Evol. 2014, 21, 593–601. [Google Scholar] [CrossRef] [PubMed]
- Azam, A.H.; Tanji, Y. Peculiarities of Staphylococcus aureus phages and their possible application in phage therapy. Appl. Microb. Biotechnol. 2019, 103, 4279–4289. [Google Scholar] [CrossRef]
- Fokine, A.; Rossmann, M.G. Molecular architecture of tailed double-stranded DNA phages. Bacteriophage 2014, 4, e28281. [Google Scholar] [CrossRef]
- Bourdin, G.; Navarro, A.; Sarker, S.A.; Pittet, A.C.; Qadri, F.; Sultana, S.; Cravioto, A.; Talukder, K.A.; Reuteler, G.; Brussow, H. Coverage of diarrhoea-associated Escherichia coli isolates from different origins with two types of phage cocktails. Microb. Biotechnol. 2014, 7, 165–176. [Google Scholar] [CrossRef]
- IR Spectrum Table & Chart. Available online: https://www.sigmaaldrich.com/LV/en/technical-documents/technical-article/analytical-chemistry/photometry-and-reflectometry/ir-spectrum-table (accessed on 27 October 2022).
- Peretz, S.; Florea-Spiroiu, M.; Anghel, D.-F.; Bala, D.; Stoian, C.; Zgherea, G. Preparation of porous calcium alginate beads and their use for adsorption of O-nitrophenol from aqueous solutions. Microfluid Nanoeng. 2013, 22, 123–136. [Google Scholar]
- Pang, Y.; Xi, F.; Luo, J.; Liu, G.; Guo, T.; Zhang, C. An alginate film-based degradable triboelectric nanogenerator. RSC Adv. 2018, 8, 6719–6726. [Google Scholar] [CrossRef]
- Olszak, T.; Zarnowiec, P.; Kaca, W.; Danis-Wlodarczyk, K.; Augustyniak, D.; Drevinek, P.; de Soyza, A.; McClean, S.; Drulis-Kawa, Z. In vitro and in vivo antibacterial activity of environmental bacteriophages against Pseudomonas aeruginosa strains from cystic fibrosis patients. Appl. Microbiol. Biotechnol. 2015, 99, 6021–6033. [Google Scholar] [CrossRef]
- Jurczak-Kurek, A.; Gasior, T.; Nejman-Falenczyk, B.; Bloch, S.; Dydecka, A.; Topka, G.; Necel, A.; Jakubowska-Deredas, M.; Narajczyk, M.; Richert, M.; et al. Biodiversity of bacteriophages: Morphological and biological properties of a large group of phages isolated from urban sewage. Sci. Rep. 2016, 6, 34338. [Google Scholar] [CrossRef] [PubMed]
- Cobb, L.H.; Park, J.; Swanson, E.A.; Beard, M.C.; McCabe, E.M.; Rourke, A.S.; Seo, K.S.; Olivier, A.K.; Priddy, L.B. CRISPR-Cas9 modified bacteriophage for treatment of Staphylococcus aureus induced osteomyelitis and soft tissue infection. PLoS ONE 2019, 14, e0220421. [Google Scholar] [CrossRef] [PubMed]
- Ma, Y.; Pacan, J.C.; Wang, Q.; Sabour, P.M.; Huang, X.; Xu, Y. Enhanced alginate microspheres as means of oral delivery of bacteriophage for reducing Staphylococcus aureus intestinal carriage. Food Hydrocoll. 2012, 26, 434–440. [Google Scholar] [CrossRef]
- Barros, J.A.R.; Melo, L.D.R.; Silva, R.A.R.D.; Ferraz, M.P.; Azeredo, J.C.V.R.; Pinheiro, V.M.C.; Colaco, B.J.A.; Fernandes, M.H.R.; Gomes, P.S.; Monteiro, F.J. Encapsulated bacteriophages in alginate-nanohydroxyapatite hydrogel as a novel delivery system to prevent orthopedic implant-associated infections. Nanomedicine 2020, 24, 102145. [Google Scholar] [CrossRef] [PubMed]

| Pyo Bacteriophages | Staph Bacteriophages | |||
|---|---|---|---|---|
| Titre, PFU/mL | Titre Reduction, Log Units | Titre, PFU/mL | Titre Reduction, Log Units | |
| Expected | 1.6 × 109 | 0.22 ± 0.01 | 5.0 × 108 | 0.30 ± 0.02 |
| Measured | (9.6 ± 0.3) × 108 | (2.5 ± 0.1) × 108 | ||
| Stock Solution, PFU/mL | Titre after Drying at 40 °C, PFU/mL | |||
|---|---|---|---|---|
| 5 h | 24 h | 144 h | ||
| Stock solution of Pyo bacteriophages | 4.8 × 108 | N/D * | N/D | N/D |
| Pyo bacteriophages/ Na-alginate | (2.2 ± 0.7) × 108 | (1.2 ± 0.2) × 108 | (1.3 ± 0.2) × 108 | 0 |
| Titre, PFU/mL | Titre Reduction, Log Units | ||
|---|---|---|---|
| Expected | 2.4 × 108 | 0.03 ± 0.01 | 0.05 ± 0.01 |
| Na-alginate solution | (2.2 ± 0.7) × 108 | ||
| 0.01 ± 0.01 | |||
| Ca-alginate hydrogel | (2.1 ± 0.2) × 108 | ||
Publisher’s Note: MDPI stays neutral with regard to jurisdictional claims in published maps and institutional affiliations. |
© 2022 by the authors. Licensee MDPI, Basel, Switzerland. This article is an open access article distributed under the terms and conditions of the Creative Commons Attribution (CC BY) license (https://creativecommons.org/licenses/by/4.0/).
Share and Cite
Stipniece, L.; Rezevska, D.; Kroica, J.; Racenis, K. Effect of the Biopolymer Carrier on Staphylococcus aureus Bacteriophage Lytic Activity. Biomolecules 2022, 12, 1875. https://doi.org/10.3390/biom12121875
Stipniece L, Rezevska D, Kroica J, Racenis K. Effect of the Biopolymer Carrier on Staphylococcus aureus Bacteriophage Lytic Activity. Biomolecules. 2022; 12(12):1875. https://doi.org/10.3390/biom12121875
Chicago/Turabian StyleStipniece, Liga, Dace Rezevska, Juta Kroica, and Karlis Racenis. 2022. "Effect of the Biopolymer Carrier on Staphylococcus aureus Bacteriophage Lytic Activity" Biomolecules 12, no. 12: 1875. https://doi.org/10.3390/biom12121875
APA StyleStipniece, L., Rezevska, D., Kroica, J., & Racenis, K. (2022). Effect of the Biopolymer Carrier on Staphylococcus aureus Bacteriophage Lytic Activity. Biomolecules, 12(12), 1875. https://doi.org/10.3390/biom12121875

